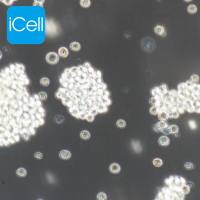
GH3 大鼠垂体瘤细胞/STR鉴定/镜像绮点(Cellverse)

相关产品推荐更多 >
万千商家帮你免费找货
0 人在求购买到急需产品
- 详细信息
- 询价记录
- 文献和实验
- 技术资料
- 英文名:
-
- 库存:
500
- 供应商:
镜像绮点
- 肿瘤类型:
-
- 细胞类型:
-
- 品系:
细胞系
- 组织来源:
子宫组织
- 相关疾病:
-
- 物种来源:
羊
- 免疫类型:
否
- 细胞形态:
铺路石状细胞
- 是否是肿瘤细胞:
否
- 器官来源:
子宫组织
- 运输方式:
冻存/复苏
- 年限:
长期
- 生长状态:
贴壁生长
- 规格:
T25
细胞详述
子宫内膜是指构成哺乳类子宫内壁的一层。子宫内膜对动情素和孕激素都起反应,因此可随着性周期(发情周期、月经周期)发生显著的变化。子宫内膜覆盖着粘膜,由粘膜上皮与其下方的固有层所组成。粘膜上皮为柱状上皮、立方上皮或复层柱状上皮,动情素分泌时,各上皮细胞将长大、分裂使数目增多。
该细胞通过慢病毒转染的方式携带SV40基因。
注意事项: 收到细胞后第一次传代建议1:2传代,充液培养基是维持培养基,不能用来培养细胞。
细胞特性
1) 组织来源于实验动物羊的正常子宫组织。
2) 细胞鉴定:广谱角蛋白(PCK)免疫荧光染色为阳性。
3) 经鉴定细胞纯度高于90%。
4) 不含有 HIV-1、 HBV、HCV、支原体、细菌、酵母和真菌。
5) 细胞生长方式:铺路石状细胞,不规则细胞,贴壁培养。
推荐培养基
我们推荐使用iCell原代上皮细胞培养体系(产品编号:PriMed-iCELL-001)作为体外培养羊子宫内膜上皮细胞永生化的培养基。
|
名称 |
体积 |
浓度 |
保存条件 |
|
原代上皮细胞基础培养基 |
500ml |
1× |
4℃、避光 |
|
原代上皮细胞培养添加剂 |
5ml |
100× |
-20℃、避光 |
|
胎牛血清(FBS) |
10ml |
终浓度2% |
-20℃、避光 |
|
双抗(青霉素/链霉素,P/S) |
5ml |
100× |
-20℃、避光 |
业务范围



风险提示:丁香通仅作为第三方平台,为商家信息发布提供平台空间。用户咨询产品时请注意保护个人信息及财产安全,合理判断,谨慎选购商品,商家和用户对交易行为负责。对于医疗器械类产品,请先查证核实企业经营资质和医疗器械产品注册证情况。
- 作者
- 内容
- 询问日期
文献和实验查看细胞文献:www.icellbioscience.com/news/News/microspace/1
技术资料